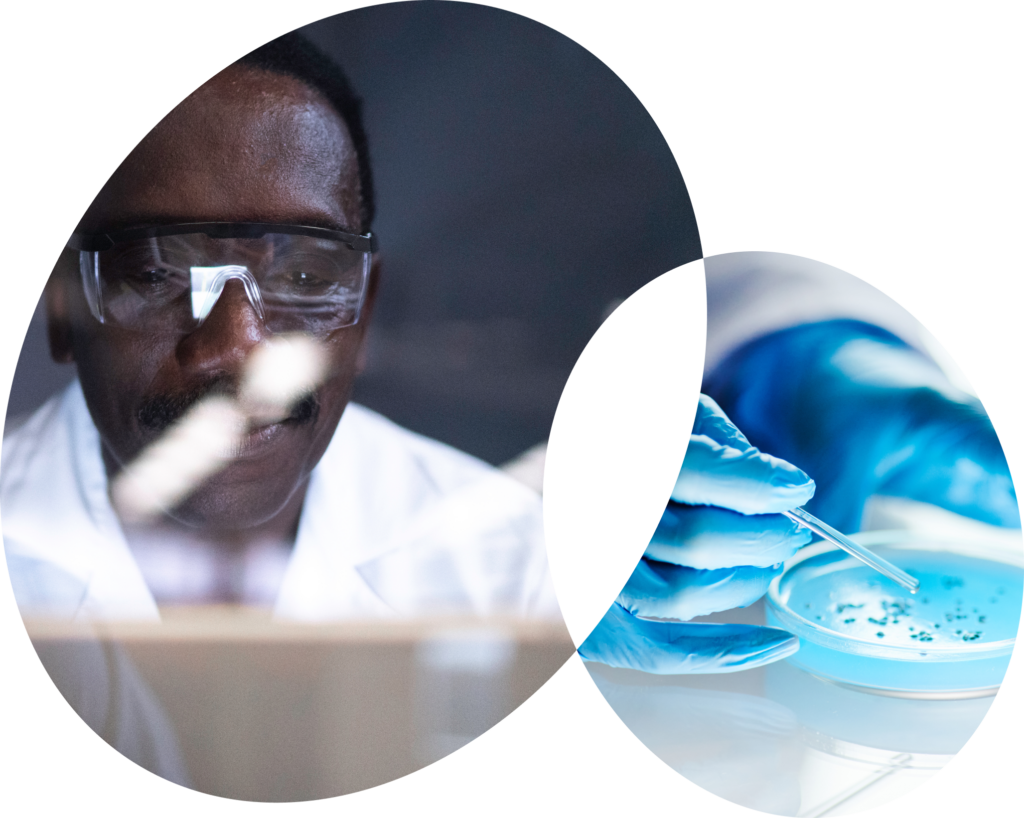

Why Syner-G
From science to success, we’ll see you through.
Accelerating progress from discovery to commercialization and every milestone in between.

We help innovators turn science into successful outcomes.
By combining scientific depth, operational strength, and strategic insight, we help guide innovators through the complexity of drug development and delivery so their science can make its greatest impact.

Your strategic development and delivery partner.
We accelerate development, reduce risk, and maximize market impact.
Our ApproachHow We Are Different
A unique combination of scientific, operational, and strategic expertise.
We are a first-of-its-kind partner that brings together scientists, engineers, regulatory and quality experts, and business strategists to deliver the integrated solutions biopharmas need across the development lifecycle.
Our Unique Approach
Connected Thinking
Our convergence of science, strategy, and delivery isn't just about breadth of services, it's about connecting those services to find new opportunities and eliminate obstacles. From regulatory affairs and CMC to business transformation and technical operations, we align every function to move with clarity, control, and speed.
Champions of Science
At our core, we are scientists, thinkers, and problem-solvers who believe in the power of science to change lives. Whether navigating regulatory pathways or optimizing formulation strategies, we advocate for the science at every turn, ensuring that rigor, integrity, and innovation stay at the forefront.
Connected Teams
Quality outcomes come from quality people on committed teams. That’s why Syner-G is a firm of full-time employees, not a patchwork of contractors. The result is stable, high-performing teams who know your business, stick by you, and deliver. It’s the difference between being project-driven and purpose-driven.
Highly-Collaborative
We meet you where you are and embed with your team to solve problems in real time. Our flexible model allows us to tailor each engagement around your needs, goals, and internal capabilities. It’s not a one-size-fits-all approach. It’s about maximizing value for every client, every time.
Commitment to Excellence
Our teams work on the frontlines of drug development every day. We know what’s at stake and what it takes to navigate complexity, manage risk, and move programs forward. It takes real-world insight, operational rigor, and relentless commitment. That’s what delivers results and that’s what keeps >90% of our clients coming back.
Our Solutions
Science + Strategy + Delivery
As a strategic development and delivery partner, Syner-G offers integrated support across every phase of the development lifecycle. Whether you’re advancing a new therapeutic through early-stage studies or scaling for commercialization, our three core solution areas work in concert to move your program forward—with clarity, efficiency, and confidence.

Scientific, Regulatory & Quality
Deep scientific and regulatory expertise to help you design, de-risk, and advance therapies efficiently from discovery through approval and beyond.
Learn More

Strategy & Transformation Consulting
Top-tier consulting talent with biotech fluency driving business performance, change readiness, and long-term growth across your organization.
Learn More

Technical Operations & Delivery Infrastructure
Operational leadership and hands-on technical execution to help you scale smartly, streamline compliance, and get to market faster.
Learn More
Let us help you find the way.
Let’s Talk